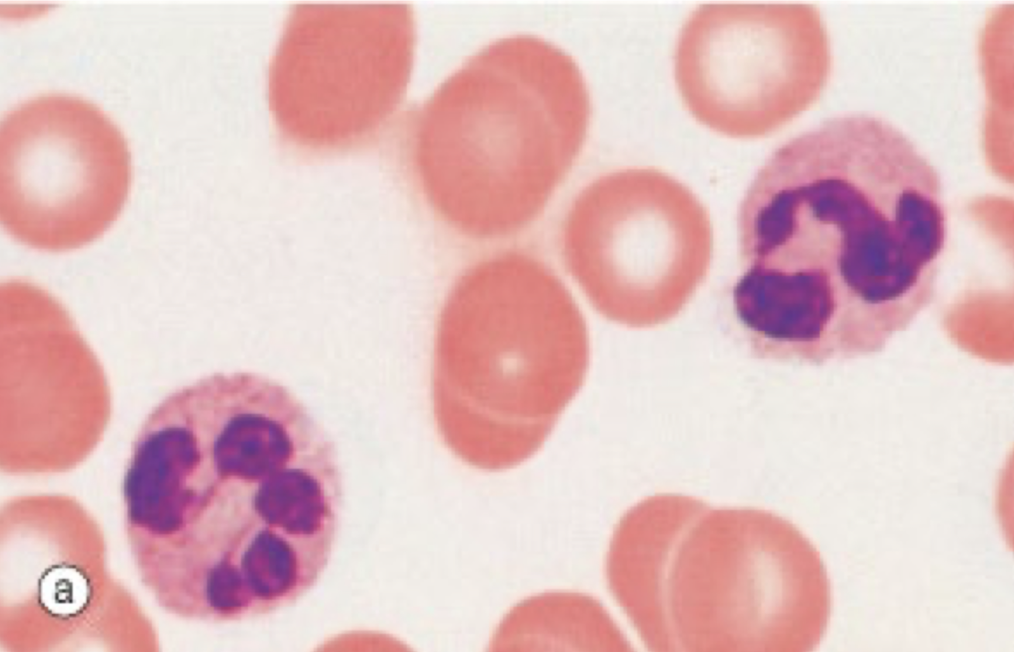
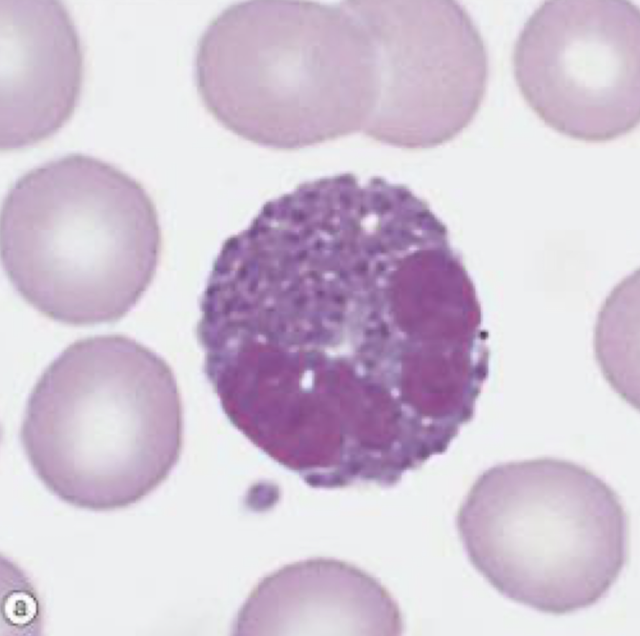
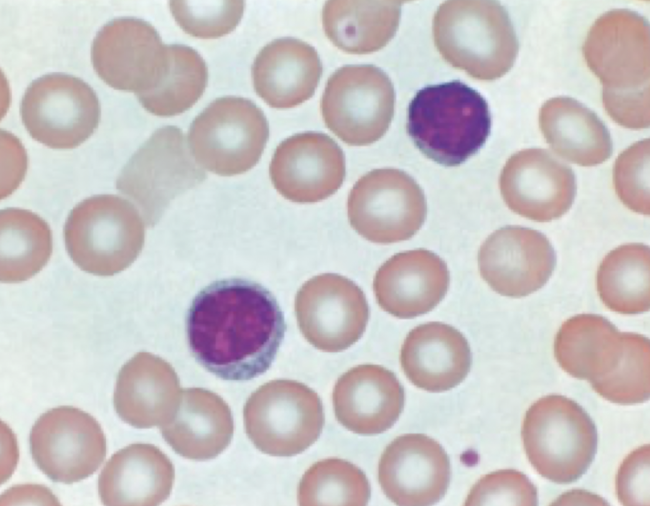
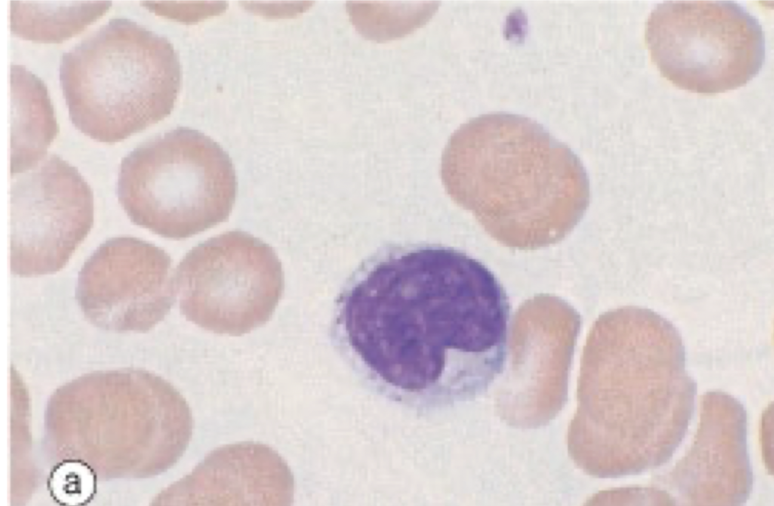
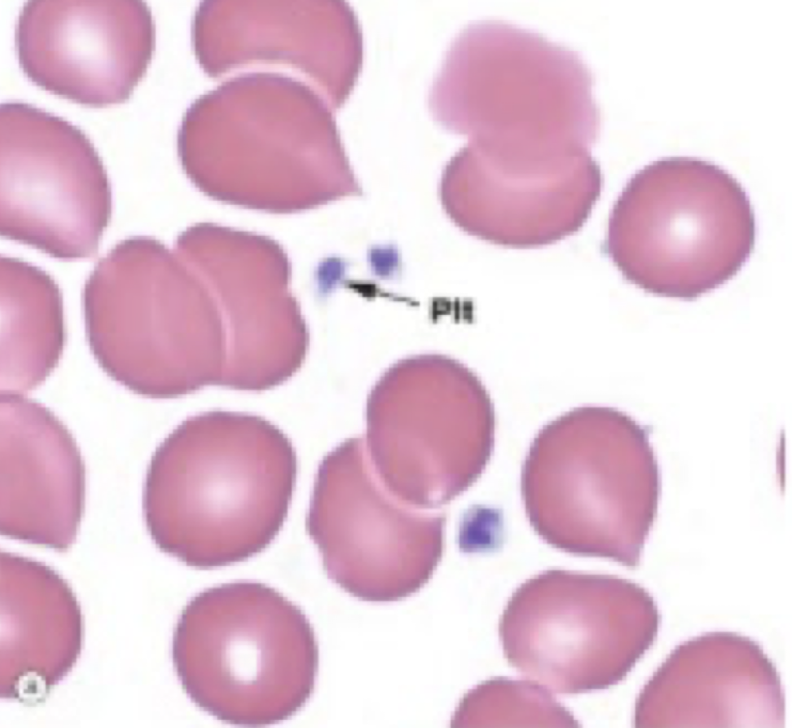

Nomme les 3 constituants cellulaires du tissu sanguin
1 - Globules rouges (érythrocytes)
2 - Globules blancs (leucocytes)
3 - Plaquettes (thrombocytes)
Nomme les fonctions et décris la morphologie des GR
Fonctions :
- Transport de l’oxygène
(par diffusion des alvéoles pulmonaires aux capillaires sanguins)
Morphologie :
- Immobiles (pas flagelles/pseudopodes)
- Disque biconcave
- Anucléé
- Membrane plasmique + cytosquelette
Nomme les fonctions et décris la morphologie des NEUTROPHILES (GB)
Fonctions :
- Action anti-infectieuse immédiate + non spécifique
- Phagocyte
Morphologie :
- Noyau multilobé
- Polynuclée
- Pseudopode
- Taille moyenne (mais la + petite des granulés)
Nomme les fonctions et décris la morphologie des ÉOSINOPHILES (GB)
Fonctions :
- Effet cytotoxique
- Effet facilitateur de phagocytose
- Faible phagocytose
Morphologie :
- Noyau bilobé
- + grand que neutrophile

Nomme les fonctions et décris la morphologie des BASOPHILES (GB)
Fonctions :
- Empêche coagulation (dans vaisseaux sanguins)
- Augmente perméabilité des capillaires
Morphologie :
- Noyau bilobé
- Gros granules
- Taille intermédaire entre éosinophile et neutrophile
Nomme les fonctions et décris la morphologie des LYMPHOCYTES (GB)
Fonctions :
- Sécrétion des anticorps (par lymphocytes B devenus plasmocytes)
Morphologie :
- PLus petites de la lignée blanche
- Gros noyau rond, cyto mince et non granulaire
Nomme les fonctions et décris la morphologie des MONOCYTES (GB)
Fonctions :
- Phagocytose
Morphologie :
- les + plus gros leucocytes
- Grand noyau excentrique, (souvent indentation profonde) - fer à cehval
- Aspect verre dépoli
-
Nomme les fonctions et décris la morphologie des PLAQUETTES
Fonctions :
- Formation clou plaquettaire
(Prévention de l’hémorragie)
Morphologie :
- Fragments cytoplasmiques
- Membrane détachée des mégacaryocytes
Nomme les solutions ou type de cellules sanguines associés aux formes des globules rouges sur l’image


Provenance des :
1) GR
2) Neutrophiles
3) Éosinophiles
4) Basophiles
5) Lymphocytes
6) Monocytes
7) Plaquette
1) GR : érythroblaste *
2) Neutrophiles : Myéloblaste *
3) Éosinophiles : Myéloblaste *
4) Basophiles : Myéloblaste *
5) Lymphocytes : Progéniteur lymphoïde
6) Monocytes : Monoblaste *
7) Plaquette : Mégacaryocyte <– Mégacaryoblaste *
- *Provient d’un progéniteur myéloïde
Effets des cytokines (2) régulatrices de l’hématopoïèse :
- Érythropoïétine (EPO)
- Production GR - Thrombopoïétine (TBO)
- Production mégacaryocytes et GR
À quoi correspond le principe de l’hémostase
Phénomène naturels qui permettent l’arrêt du saignement en trois phases
À quoi correspond l’étape de l’hémostase primaire (4)
[comprendre le principe]
- Bris de paroi endothéliale du vaisseau sanguin
- Liaison plaquettes-collagène (via facteurs coagulation + glycoprotéines)
- Recrutement fibrinogène (forme clou)
- Expression phopholipides des plaquettes
À quoi correspond l’étape de la coagulation plasmatique (3)
[comprendre le principe]
- Activation prothrombine en thrombine (via facteurs de coagulation + phopholipides)
- Fibrinogène converti en fibrine
- Inhibition coagulation
À quoi correspond l’étape de la fibrolyse (1)
[comprendre le principe]
- Resolubilisassions de la fibrine
Explique le fonctionnement des sarcomères
Sarcomère = unité des myofibrille responsable de la contraction des fibres musculaires
- Bande H : zone myosine seulement
- Bande I : zone actine seulement
- Ligne Z : Limites sarcomère (actine retenue ici)
- Ligne M : Zone discoïde (myosine retenue ici)
- À l’état contraction : bande H et I se chevauchent

Explique la contraction musculaire :
(implication de la jonction neuromusculaire/actine/myosine/Ca2+)
1 - PA envoie l’ACh à la jonction neuromusculaire
2 - Récepteurs cholinergiques du sarcolemme = déclenchement relâche du Ca2+ dans RE
3 - Calcium se fixe sur troponine = changement de conformation de l’actine
4 - Déplacement de tropomyosine = libération site sur actine = contact tête myosine-site.
5 - Chevauchement actine-myosine = contraction
Nomme les 3 types de tissus musculaires
1 - Muscle SQUELETTIQUE (strié)
2 - Muscle LISSE
3 - Muscle CARDIAQUE
Caractéristiques (7) du muscle SQUELETTIQUE
1 - Contrôle de posture + mouvements
2 - Volontaire
3 - Cellules volumineuses/allongées/1m de long possible
4 - Polynucléées (en situation périphérique)
5 - Fibres < faisceaux < endomysium < péri < épi
6 - Striations transversales = organisation myofribrilles
7 - Mécanisme contraction par glissement filaments

Caractéristiques (7) du muscle LISSE
1 - Composition des structures viscérales (vx sanguins/tractus gastro-intestinal/utérus/vessie)
2 - Involontaire / autonome
3 - Petites cellules fusiformes
4 - 1 noyau central
5 - Réseau collagène (en périphérie)
6 - Pas de striations (myofibrilles sur corps dense)
7 - Cellules raccourcies et épaissies lors de contractions

Caractérsistiques (6) du muscle CARDIAQUE
1 - Contractibilité rythmique/continue du coeur
2 - Cellules ramifiés / allongées / interconnectées
3 - Noyau unique central (+ qq cellules bi-nucléées)
4 - Involontaire / spontanément contractile / autonome
5 - Striations transversales (disques intercalaires)
6 - Mécanisme contraction par glissement filaments

1) Qu’est-ce qui entoure les fibres musculaires ?
2) Qu’est-ce qui sépare les faisceaux (regroupement de fibres) ?
3) Qu’est-ce qui entoure les faisceaux et le Périmysium ?
1) Fibres entourées par ENDOMYSIUM
2) Faisceaux séparés par PÉRIMYSIUM (tissu conjonctif lâche)
3) Faisceaux et Périmysium entouré par ÉPIMYSIUM
(tissu conjonctif dense orienté)

Caractéristiques (5) fibres aérobiques ou rouge ou type 1
- Contraction lente
- Riche en myoglobines et mitochondries
- Richement vascularisées
- Posture et endurance
- PEU D’HYPERTROPHIE
Caractéristiques (6) fibres anaérobiques ou blanche ou type 2
- Contraction rapide
- plus volumineuse
- Riche en glycogène
- Puissance sur courte période
- HYPERTROPHIE
- Relation dense avec tissu nerveux


